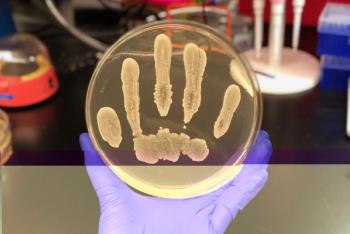

News
Advertisement
Advertisement
Trending on Infection Control Today
1
Announcing the 2025 Infection Control Today Educator of the Year Award Winner: Patricia Montgomery, MPH, RN, CIC, FAPIC
2
The Invisible Threats: An IP's Guide to Advocating for Sterile Processing
3
The Clean Bite: Real Talk About Infection Control – Creating an Effective Dental Infection Prevention Training Program
4
Always On: How Copper Linens Shift Both Safety and Spending
5